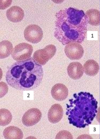

Lecture 3 Flashcards
(45 cards)
Identify the following cell types.
- Eosinophil.
- Neutrophil.
- Basophil.

Define “acute inflammation.”
Accumulation of neutrophils in the tissues.
What is pus composed of?
Dead and dying neutrophils.
True or False: Neutrophils have uncondensed chromatin, so they can readily regenerate.
FALSE
Neutrophils have condensed chromatin. They are short-lived, end-stage cells.
What might you find in a neutrophil’s vesicles?
Proteolytic enzymes
Bacteriocides
Glycogen
How long will a neutrophil live in normal (uninflamed) tissue?
1-2 days.
How long does a neutrophil normally circulate in the blood stream?
8-10 hours.
True or False: Neutrophils require specific antigens in order to attack pathogens.
FALSE
Neutrophils are part of the innate immune system and do not respond to specific antigens.
Neutrophils store glycogen, which is unusual amongst leukocytes. What do they use it for?
Anaerobic respiration.
Useful for penetrating damaged tissue where the oxygen supply may be cut off.
Neutrophils are not perfectly circular, but have a lot of extra membrane. Why is this?
Phagocytosis.
Motility.
Name the four major receptor types on the neutrophil surface.
Cell adhesion molecules.
Antibody receptor (FcR).
Complement receptors.
Cytokine (inflammatory mediator) receptors.
What is the term for a neutrophil slowly rolling along a blood vessel?
Margination.
Where does neutrophil margination occur?
Post-capillary venules.
What is the term for an acute neutrophilia in the blood induced by fear, epinephrine, or glucocoritcoids?
Stress leukogram.
How do anti-inflammatories affect neutrophils?
They disrupt margination, preventing neutrophils from migrating to target tissues.
Which endothelial molecules are responsible for neutrophil rolling?
Selectins.
Which endothelial molecules are responsible for neutrophil sticking (i.e. cause the neutrophil to stop rolling)?
Integrins.
Define diapedesis.
The passage of a cell through the intact endothelial layer to reach a target tissue.
In neutrophils, diapedesis occurs after the neutrophil has encountered integrin molecules.
Define chemotaxis.
The movement of a cell in response to chemical stimuli.
Neutrophils rely on chemotaxis to locate bacteria in the tissues.
Define opsonization.
When a pathogen is marked and prepared for phagocytosis.
Opsonin molecules may include:
Antibody
Complement molecules
Some acute phase proteins
What is the name of the pictured process?

Diapedesis.
This is a neutrophil squeezing in between endothelial cells.
True or False: A neutrophil will not bind to anything more hydrophilic than itself.
TRUE
Neutrophils can bind to objects that are more hydrophobic than themselves.
What is the term for an engulfed membrane-bound vesicle containing a microbe?
Phagosome.


